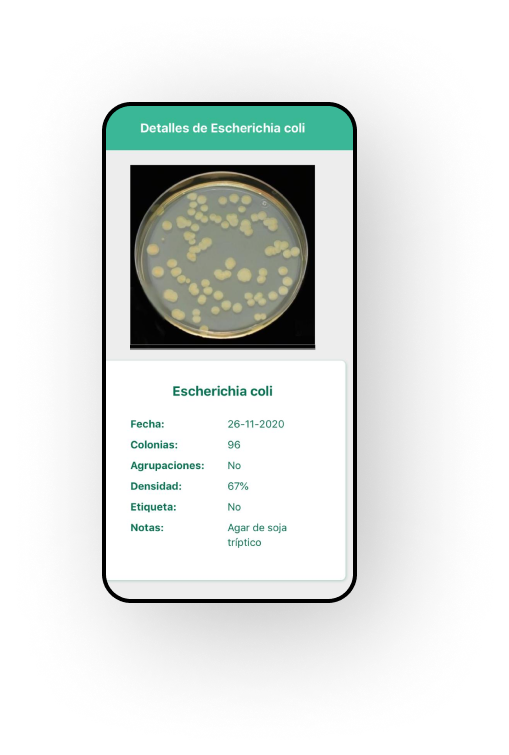

Una alternativa confiable y automática del proceso de recuento de colonias y área ocupada por bacterias sobre el total del cultivo

Una alternativa confiable y automática del proceso de recuento de colonias y área ocupada por bacterias sobre el total del cultivo
Nuestra App realiza el recuento automatizado de unidades formadoras de colonias (UFC) bacterianas en un cultivo
Cálculo automático de área cubierta por bacterias por sobre área total del cultivo
Proveemos una base de datos de pacientes, cultivos y resultados para centros de salud que no la tengan disponible

Entre los proyectos de 1000 alumnos para el premio en su Octava edición, elegido por el Ministro de educación Nicolás Trotta y la Ministra de educación de CABA Soledad Acuña, entre otros

Image Processing

Backend developer

Image processing

Project Manager

Frontend Developer